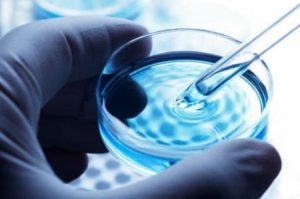
Процедура Эко

Метод ИКСИ произвел революцию в лечении мужского бесплодия, подарив надежду мужчинам, которые ранее не могли претендовать на генетическое отцовство. Израильские клиники одними из первых начали практиковать инновационную методику, что позволило местным врачам накопить большой опыт и разработать эффективные протоколы лечения.
Технологию ИКСИ можно применять даже если имеется очень небольшое количество спермы. Также неважно, обладают ли сперматозоиды способностью проникать в яйцеклетку, так как этот механизм воспроизводится искусственно. Процедура ИКСИ в Израиле полностью изменила курс лечения мужского бесплодия, помогая до 95% пар, для которых ранее единственным выходом было использование донорской спермы или усыновление ребенка.
Ведущие клиники в Израиле
Основные преимущества ИКСИ в Израиле:
- Тщательная подготовка к процедуре. В израильских клиниках мужчины проходят комплексную подготовку, курируемую опытными андрологами и урологами. При необходимости они проводят операционное извлечение спермы с применением минимально инвазивных подходов.
- Опытные эмбриологи. Успешность оплодотворения методом ИКСИ во многом зависит от мастерства эмбриолога. В клиниках Израиля процедура проводится врачами, обладающими большим опытом в этой области. В их распоряжении лаборатории, оснащенные сложным современным оборудованием.
- Персонализированный подход. Израильские врачи тщательно рассматривают каждый конкретный случай, чтобы учесть все индивидуальные особенности партнеров. Есть возможность проведения частичной ИКСИ. Она предполагает проведение цитоплазматической инъекции на половине имеющихся яйцеклеток и стандартной процедуры ЭКО на другой. Этот метод подходит для лечения пар с бесплодием неясного генеза.
ИКСИ в Израиле: показания к лечению
 Мужской фактор бесплодия присутствует примерно у 40% всех пар. Благодаря методике ИКСИ отцовство стало возможным даже при наличии только одного сперматозоида. Это особенно важно для мужчин, которые не в состоянии производить сперму путем эякуляции, но до сих пор имеют небольшое количество жизнеспособных сперматозоидов в яичках или придатках. Примерами являются отсутствие семявыносящего протока, перенесенная вазэктомия, неудавшаяся вазовазостомия, а также некоторые заболевания, при которых уменьшается число нормальных сперматозоидов в эякуляте. В этих случаях небольшое количество спермы может быть получено посредством минимально инвазивной хирургии.
Мужской фактор бесплодия присутствует примерно у 40% всех пар. Благодаря методике ИКСИ отцовство стало возможным даже при наличии только одного сперматозоида. Это особенно важно для мужчин, которые не в состоянии производить сперму путем эякуляции, но до сих пор имеют небольшое количество жизнеспособных сперматозоидов в яичках или придатках. Примерами являются отсутствие семявыносящего протока, перенесенная вазэктомия, неудавшаяся вазовазостомия, а также некоторые заболевания, при которых уменьшается число нормальных сперматозоидов в эякуляте. В этих случаях небольшое количество спермы может быть получено посредством минимально инвазивной хирургии.
Основными показаниями к процедуре являются:
- Предыдущие неудачи при стандартном экстракорпоральном оплодотворении
- Крайне низкое количество сперматозоидов
- Плохая подвижность сперматозоидов
- Обструкция семявыносящего протока
- Размороженный образец предположительно имеет пониженный потенциал для оплодотворения
- Сперма была собрана хирургическим путем
- В сперме присутствует высокий уровень антител
Принимать решение о проведении ИКСИ особенно трудно при отсутствии доказательств мужского фактора бесплодия. Некоторые пары выбирают этот метод, стремясь сделать все возможное, чтобы повысить шансы на успешное оплодотворение. Тем не менее, важно понимать, что для многих пар с нормальными качествами спермы, максимальная вероятность наступления беременности может быть достигнута и при стандартной процедуре ЭКО.
Что собой представляет метод ИКСИ в Израиле
В отличии от стандартных способов искусственного оплодотворения, которые полагаются на способность сперматозоидов прикрепляться и проникать сквозь мембрану яйцеклетки, при ИКСИ этого не требуется. Сперматозоид должен быть жизнеспособный, но не обязательно подвижный. Что касается яйцеклеток, то они должны быть собраны из зрелых фолликулов. В процессе цитоплазматической инъекции яйцеклетка может быть повреждена, это означает, что только 90% оплодотворенных ооцитов выживет.
В отличии от стандартных способов искусственного оплодотворения, которые полагаются на способность сперматозоидов прикрепляться и проникать сквозь мембрану яйцеклетки, при ИКСИ этого не требуется. Сперматозоид должен быть жизнеспособный, но не обязательно подвижный. Что касается яйцеклеток, то они должны быть собраны из зрелых фолликулов. В процессе цитоплазматической инъекции яйцеклетка может быть повреждена, это означает, что только 90% оплодотворенных ооцитов выживет.
Используя сложный микроскоп с современной оптикой, каждый ооцит освобождается от окружающих его кумулюсных клеток и удерживается на месте стеклянным капилляром. Затем эмбриолог с помощью микроиглы захватывает один сперматозоид из полученного ранее образца, прокалывает зону пеллюцида и мембрану ооцита, после чего вводит сперматозоид в яйцеклетку.
Ведущие израильские гинекологи-репродуктологи
ИКСИ в клиниках Израиля проводится в несколько этапов:
- Подготовка к процедуре. Женщина проходит гормональную терапию препаратами, стимулирующими созревание сразу нескольких яйцеклеток в яичниках. Цель лечения – создание нескольких эмбрионов, из которых эмбриологи выберут самые жизнеспособные для переноса в полость матки.
- Сбор ооцитов. Врач под контролем трансвагинального УЗИ выполняет пункцию яичника. Жидкость, содержащая яйцеклетки, передается в лабораторию эмбриологии. Процедура не требует разрезов и не оставляет шрамов, так как доступ к яичнику осуществляется через влагалище.
- Сбор сперматозоидов. Если сперматозоидов в эякуляте недостаточно, врач может извлечь их из яичка или придатка путем аспирации тонкой иглой (PESA/ TESA) Когда и этот метод неэффективен, проводится хирургическое извлечение семенного материала методом биопсии.
- Оплодотворение. Израильские эмбриологи манипулируют ооцитами и сперматозоидами под контролем мощных микроскопов, выполняя очень точные хирургические процедуры с микроскопически малыми объектами. С помощью специального инструментария эмбриолог фиксирует яйцеклетку, прокалывает ее оболочку и вводит в цитоплазму сперматозоид. Процесс оплодотворения тщательно контролируется. Готовые эмбрионы перемещаются в специальный инкубатор.
- Имплантация и контроль эмбрионального развития. В течение двух суток эмбриологи наблюдают за делением клеток эмбрионов. Затем они выбирают самые здоровые и жизнеспособные образцы и переносят их в полость матки. При желании пациенты израильских клиник имеют возможность криоконсервации оставшихся жизнеспособных эмбрионов. Через несколько недель после переноса эмбриона выполняется тест на беременность. Если лечение прошло успешно, пациентка направляется в перинатальный центр и проходит регулярные УЗИ для контроля развивающейся беременности.
В клиниках Израиля успешность оплодотворения методом ИКСИ в парах с фактором мужского бесплодия составляет 70%-80%. Это эквивалент оплодотворения нормальной спермой при стандартном протоколе ЭКО. Самым важным показателем успеха ИКСИ является коэффициент успешно оплодотворенных яйцеклеток. В израильских репродуктивных клиниках он очень высокий – 80%-85%. Это означает, что, в среднем, 8 из 10 яйцеклеток оплодотворяются нормально.
Стоимость ИКСИ в Израиле
На итоговую сумму могут повлиять такие факторы, как способ подготовки партнеров, метод сбора ооцитов и сперматозоидов, технология, с помощью которой проводится цитоплазматическаяинъекция, количество попыток достижения беременности, а также необходимость дальнейшего наблюдения женщины с целью предотвращения прерывания беременности. Но при этом средние цены на ИКСИ в клиниках Израиля на 30%-50% ниже, чем в репродуктивных центрах США и стран Западной Европы.
Дополнительную информацию смотрите в разделе ЭКО.















